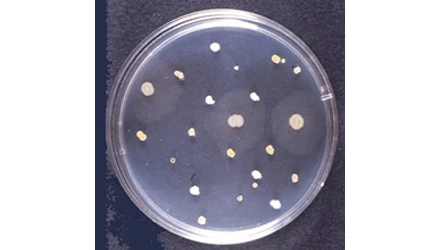
MIT JELENT A 22C -ON TENYÉSZTETT TELEPSZÁM?

TELEPSZÁM 22 °C-ON
A 22°C-on növő baktériumok telepszáma a vízhálózat általános bakteriális szennyezettségéről, valamint a hálózat és az ivóvíz bakteriális növekedést támogató állapotáról ad felvilágosítást. Ez azt jelenti, hogy nem maga a telepek száma szolgáltat számunkra információt hanem az un. normáll állapothoz képest bekövetkező változás.
Példa: Ha egy adott hálózatból vett vízmintában a jellemző telepszám 10 de az aktuális mintavétel alkalmával ez a szám már 50, akkor ez azt jelezheti, hogy a vízhálózatban szennyezés történt.
A Kormányrendelet nem határoz meg egy ekzakt értéket erre a paraméterre, hanem a telepszám szokatlan növekedése jelez problémát. A helyileg illetékes egészségügyi hatóság állapít meg parametrikus értéket a konkrét vízhálózatra jellemző alap értékek alapján.
A nagy telepszám általában a vízhálózatban történő utószaporodás következménye, amelyhez hozzájárulhat a hálózat korróziója, a víz pangása, vagy a nyersvíz nagy szervesanyag tartalma. Eredendően nagy telepszám jellemző olyan területeken is, ahol a nyersvíz hőmérséklete tartósan magas. A 22 °C-os telepszámot emberre veszélytelen környezeti baktériumok adják, jelentős egészségkockázatuk nincs.
Indikátor baktérium, azt jelzi, hogy a vízrendszerben uralkodó körülmények mennyire teszik lehetővé baktériumok szaporodását. A szolgáltató a telepszám megemelkedése esetén köteles a hiba okának felderítésére és elhárítására. Az elsődleges megoldás a hálózati ásványi vagy mikrobiális lerakódások eltávolítását célzó szivacsos mosatás.
A település vízminősége Telepszám 22°C-on paraméter tekintetében „kifogásolt” minőségű, ha a vízellátó rendszerben vett vízminták legalább 10%-ában a Telepszám 22°C-on értéke nagyobb, mint a vízellátó rendszerben meghatározott jellemző érték.